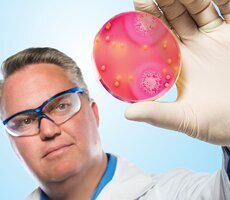

Articles

January 15, 2016
UMD, Phillips Collection Join Forces to Increase Collaboration in the Arts and Humanities

January 15, 2016
Namesake’s Place in UMD History Prompted Discussion on Diversity

January 12, 2016
Alum Is Finalist to Design WWI Monument in D.C.

January 12, 2016
Researcher Measuring Global Snow as Warming Takes Toll

January 12, 2016

January 05, 2016
Alum’s New Book Revisits America’s Bicycle Heyday

January 02, 2016

December 22, 2015
Opening Doors to Women Helps Fill Empty Computing Jobs

December 18, 2015
Community Garden Gets Refugees Growing

December 15, 2015
UMD Scientists Move a Step Closer to Explaining the Greatest Sci-fi Weapon of All Time

December 11, 2015

December 08, 2015
Partnership Spearheads Howard County Sustainability Projects
December 04, 2015
Researcher’s “Enzybiotics” a New Weapon Against Superbugs

November 30, 2015
Alum Brings Air Force Logistics Experience to Rent the Runway

November 30, 2015

November 30, 2015